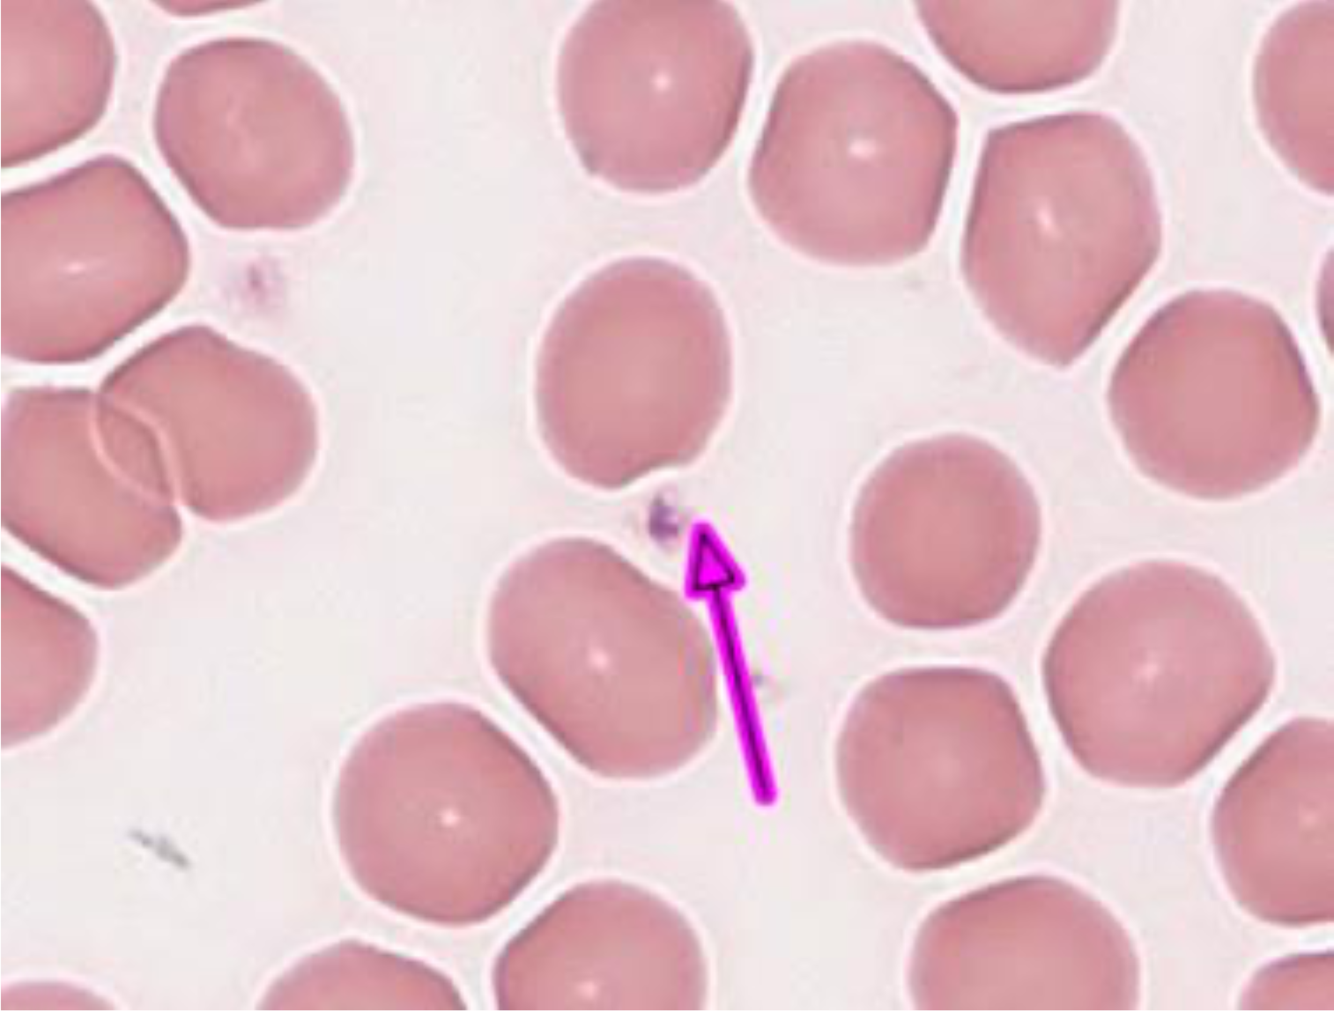
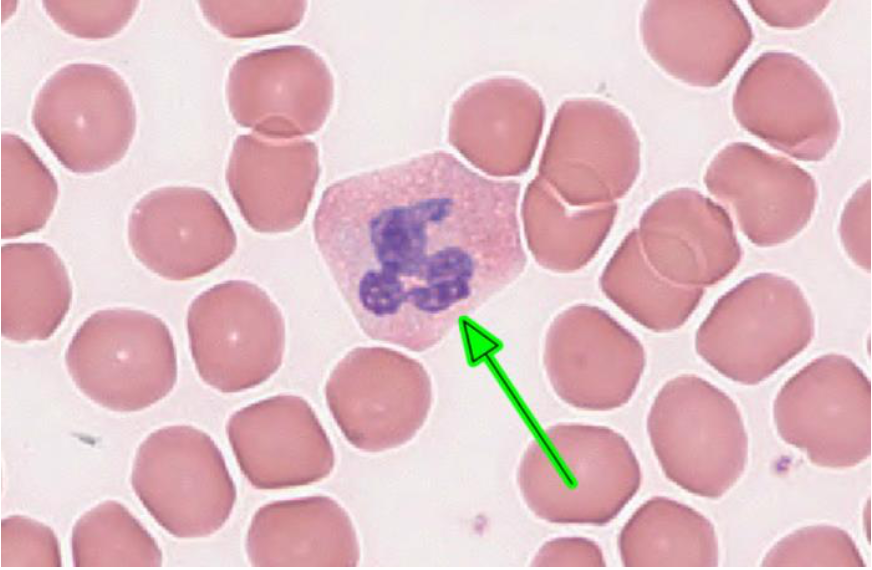
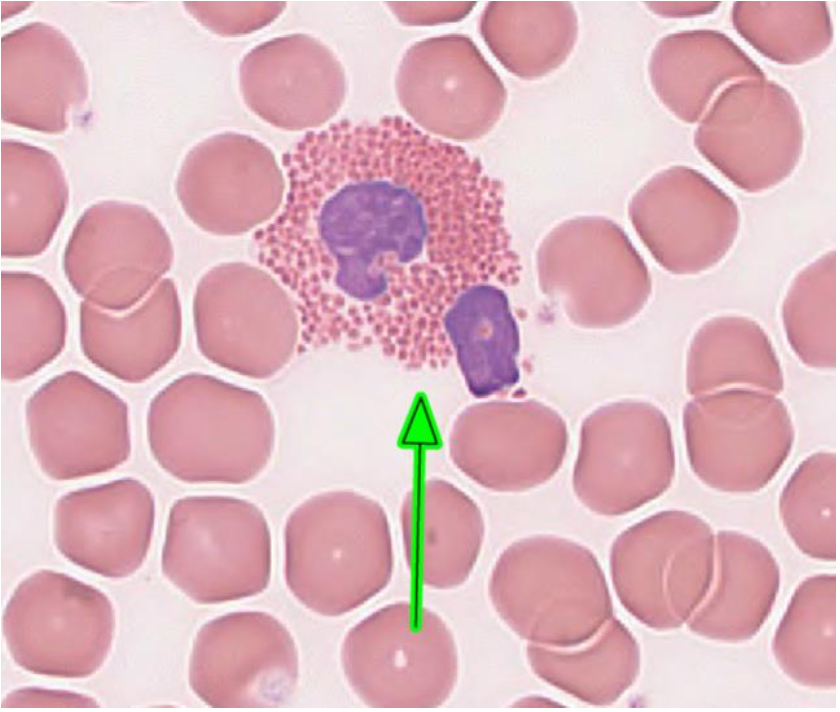
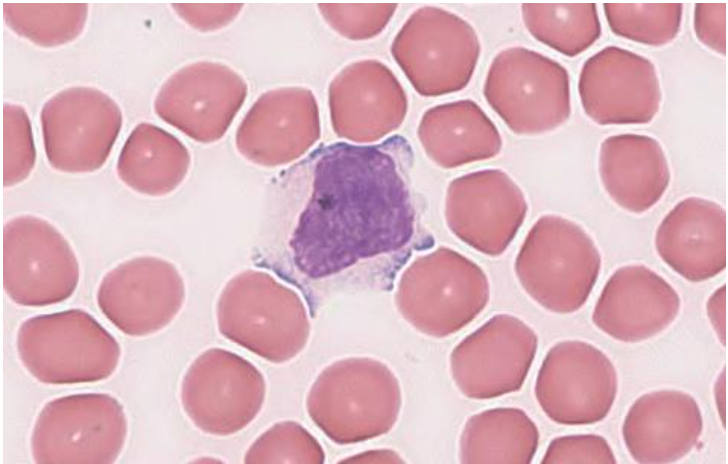
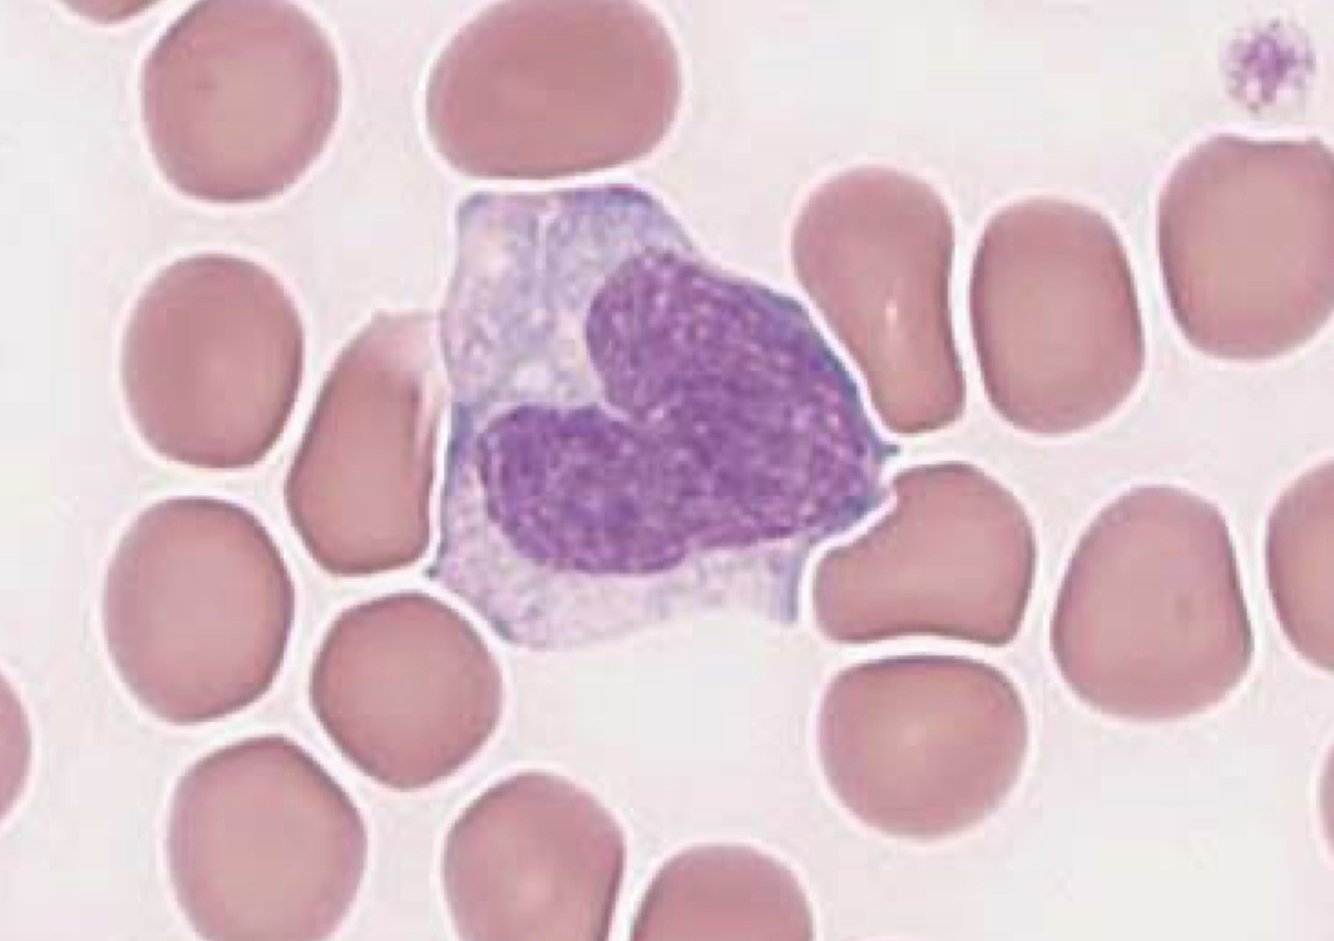
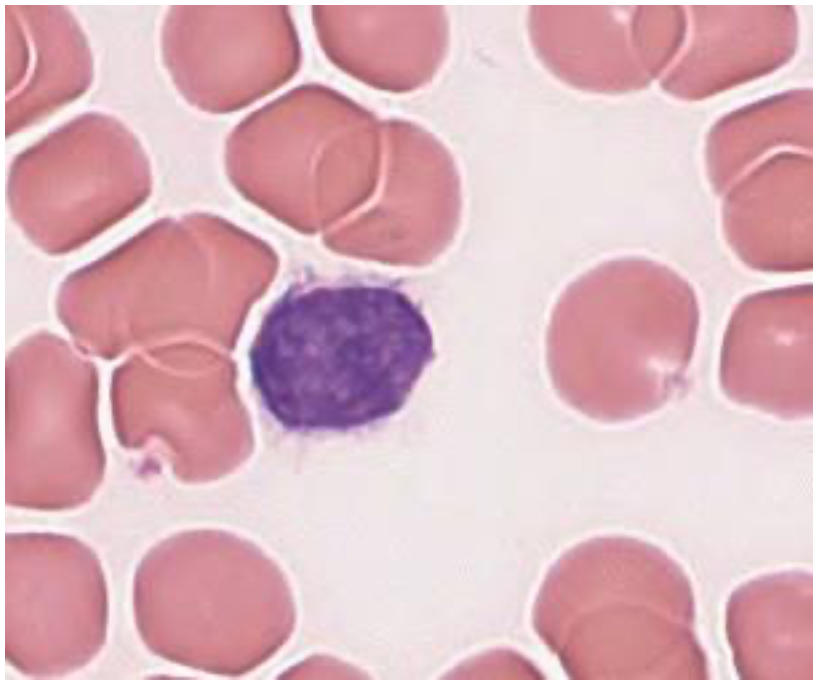
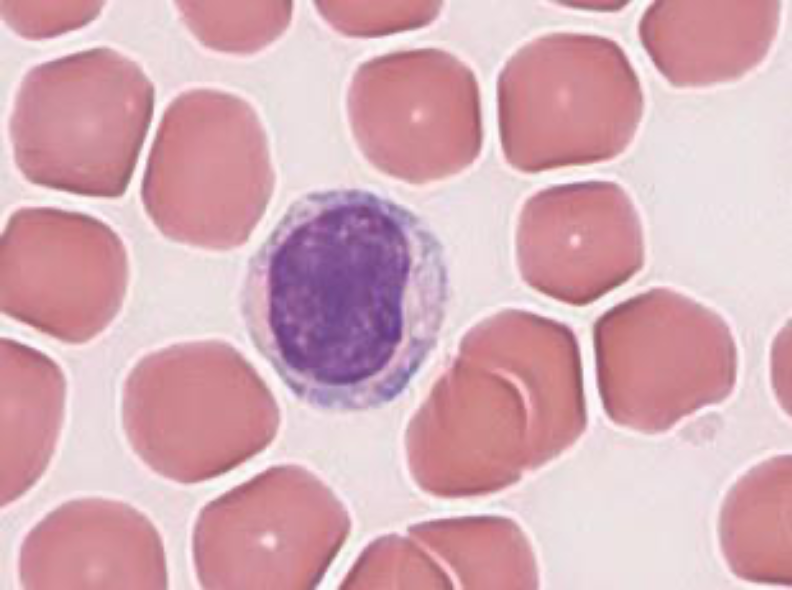

Platelet
What granulocytes are found in the peripheral blood?
Neutrophils, eosinophils, basophils
What agranulocytes are found in the peripheral blood?
Monocytes, lymphocyte
Neutrophil
Neutrophils constitute what percentage of circulating leukocytes in a normal blood smear?
They make up 48-76% of circulating leukocytes.
What is the function of neutrophils?
Neutrophils contain granules (such as primary – myeloperoxidase, elastase, antibacterial proteins, secondary – lysozyme, tertiary – alkaline phosphatase) that are responsible for fighting off local pathogens in tissue. They are fast acting and often are the first responder in an infection.
Eosinophil
Eosinophils constitute what percentage of circulating leukocytes in a normal blood smear?
Less than 5%.
What are the functions of eosinophils?
Eosinophils can seek out or dampen the inflammatory reactions and are antiparasitic.

Basophil
Basophils constitute what percentage of circulating leukocytes in a normal blood smear?
0-2% of leukocytes.
What is the primary function of basophils?
Basophils incite inflammatory responses. They bind to circulating IgE via IgE receptor on their cell surface and the IgE then binds to antigens, resulting in activation of the basophil and degranulation. Basophil granules contain histamine, which plays a big role in initiating an inflammatory response.
What resident connective tissue cell functions similarly to basophils, and shares a common progenitor cell?
Mast cells
Monocyte
Monocyte
Monocytes constitute what percentage of circulating leukocytes in a normal blood smear?
2.5-8.5%
What is the function of monocytes?
Become macrophages in tissue, engulf foreign invaders, dead tissue, tumor cells.
Small lymphocyte
Large lymphocyte
Lymphocytes constitute what percentage of circulating leukocytes in a normal blood smear?
18-41%
Name the three main classes of lymphocytes.
B cells, T cells, NK cells
Describe the morphologic differences between the erythrocytes seen in iron deficiency anemia and those in the normal blood smear.
The RBCs are smaller and have a larger central pallor, with the staining presenting mainly on the outline of the cell. The shape is consistent.